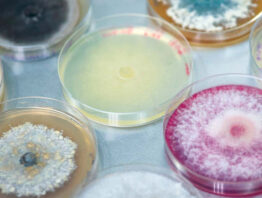
petri dishes holding microbes owned by St. Paul-based Jord BioScience

Meet 10 businesses and nonprofits moving the needle on equity, education, environment, and other pressing societal concerns.
April/May 2024 More Back issues View E-Edition
Cover Story
Featured Stories
On the precipice of its first blockbuster exhibition in years, the Walker Art Center is reexamining the relationship between art and commerce.
Gender barriers still exist for two power positions: CEO and U.S. president.
Columns
Sheletta Brundidge stands for a new era of purpose-driven leadership.
Twin Cities arts organizations innovate to get people into their concert halls and theaters.
From Elon Musk to the Michigan Wolverines, glorifying famous bullies is dangerous.
How can it be that women, who enjoy an increasing voting majority, an increasing dominance in higher education, and electoral successes at almost every level, cannot become the commander in chief?
More Stories
An accounting shortage is forcing firms and academic institutions to rethink the fundamentals of the profession.
The team's accelerator program is motivating some startups to relocate to Minnesota.
How does a city without population growth have a housing shortage?
Meet the women-run St. Paul startup taking a novel approach to agriculture.
The former chief brand officer for Deluxe Corp. is reimagining her mission without the corporate structure.
A recent study suggests women business owners hold significant untapped business planning potential. BMO shares how women can be better empowered in the marketplace.
As the demand for reliable internet connection continues to increase, future-proofing the home with a fiber-rich network isn't just an ideal—it's a necessary investment for tomorrow's living.